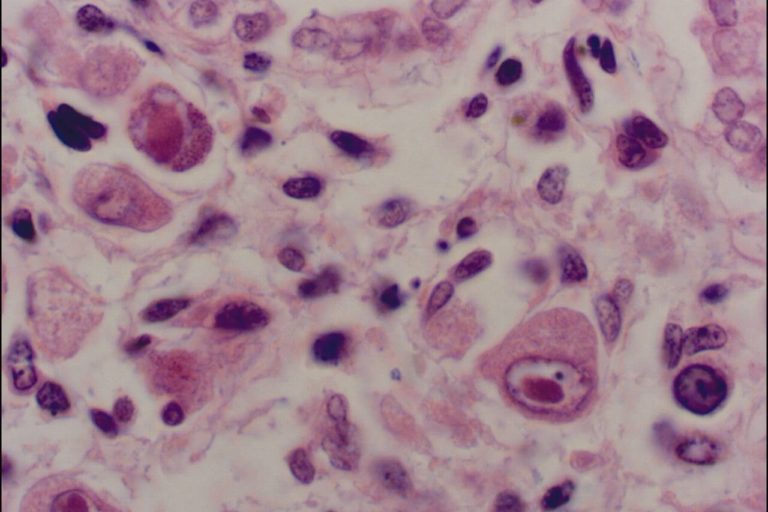

АКТУЕЛНОСТИ
Секоја информација има корисно значење, доколку добро ја разбирате и насочувате. Голем број жени имаат слабо познавање за одредени фактори поврзани со бременоста, а од кои би можело да зависи нивното здравје, нивната сигурност и информираноста за најголемата промена во нивните животи.
Водич на пациентите
За полесно пронаоѓање на информацијата која вам ви е најважна
Работи кои треба да ги знаете